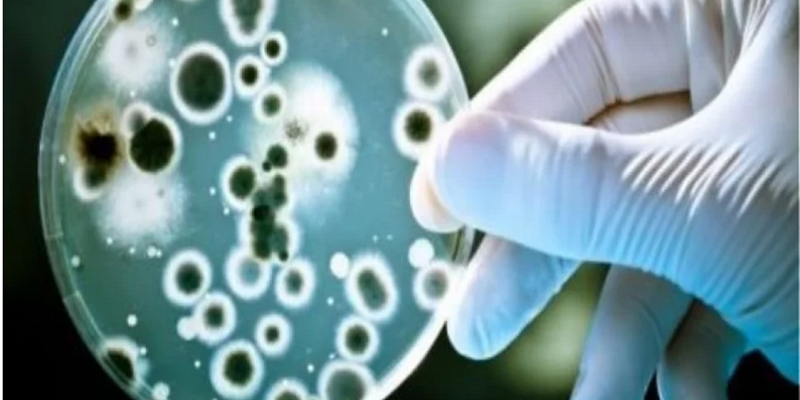

Στο στάδιο των κλινικών μελετών βρίσκονται τα πολύ μικρά νανοσωματίδια, ή αλλιώς οι «έξυπνοι» νανοφορείς, που δεν είναι εμφανή με γυμνό μάτι και τους οποίους μπορούν πλέον να αναπτύσσουν μετά από 10ετή έρευνα επιστήμονες στο Εργαστήριο Νανοτεχνολογίας του Αριστοτελείου Πανεπιστημίου Θεσσαλονίκης (ΑΠΘ), όπως τόνισε, μιλώντας στο ΑΠΕ-ΜΠΕ, η υπεύθυνη του τμήματος νανοϊατρικής, Βαρβάρα Καραγκιοζάκη, καρδιολόγος. Βασικός στόχος κάθε κλινικής μελέτης είναι να αποδείξει ότι το ερευνητικό προϊόν είναι ασφαλές και αποτελεσματικό για ανθρώπινη χρήση και «διαρκούν από δύο έως και πέντε έτη, με τα κονδύλια που απαιτούνται να κυμαίνονται από 10 έως και 20 εκατ. ευρώ», διευκρίνισε.
«Η Ελλάδα θεωρείται από τους πρωτεργάτες παγκοσμίως, στο κομμάτι της νανοϊατρικής του τομέα της νανοτεχνολογίας», υπογράμμισε η ίδια στο περιθώριο του «NANOTEXNOLOGY 2022», που διεξάγεται στη Θεσσαλονίκη και εξήγησε ότι αυτοί οι νανοφορείς, μεταφέρουν διάφορους θεραπευτικούς παράγοντες, όπως γονίδια, φάρμακα και βότανα και οτιδήποτε μπορεί να θεραπεύσει μια ασθένεια, μπορούν να διαπεράσουν κάθε βιολογικό φραγμό στον ανθρώπινο οργανισμό, φτάνοντας στις πιο απομακρυσμένες και «δύσβατες» περιοχές του ανθρώπινου οργανισμού, ενώ λειτουργούν στοχευόμενα και θεραπευτικά.
«Είναι τόσο έξυπνοι οι νανοφορείς που πάνε μόνο σε περιοχές που έχουν πρόβλημα και δεν ακουμπάνε καθόλου τα υγιή κύτταρα», σημείωσε χαρακτηριστικά και ανέφερε ενδεικτικά την σύνθεση των νανοφορέων που αναπτύσσονται στο εργαστήριο Νανοτεχνολογίας του ΑΠΘ για την αντιμετώπιση της αθηρωμάτωσης που είναι μια διαδικασία που συμβαίνει στο τοίχωμα των αρτηριών, στενεύει τις αρτηρίες και έτσι επέρχεται το έμφραγμα. Στο εργαστήριο «συνθέτουμε τέτοιους νανοφορείς, που μπορούν να μεταφέρουν θεραπευτικούς παράγοντες, όπως φάρμακα, και στοχεύουν στο να διαλύσουν τις αθηρωματικές πλάκες γλυτώνοντας έτσι από το έμφαγμα τον ασθενή», υπογράμμισε.
Οι νανοφορείς μπορούν να δράσουν σε όλα τα ζωτικά όργανα του σώματος και να αντιμετωπίσουν οποιαδήποτε ασθένεια μεταφέροντας αδιάλυτα φάρμακα. Διαπερνώντας το φραγμό του εγκεφάλου «μπορούν να αντιμετωπίσουν τον καρκίνο εγκεφάλου ή άλλες νευροεκφυλιστικές ασθένειες», τόνισε η κ. Καραγκιοζάκη, αλλά μπορούν να χρησιμοποιηθούν και από καρκινοπαθείς, «και να κατευθυνθούν σε συγκεκριμένες περιοχές, γλυτώνοντας έτσι τον ασθενή από μια γενικευμένη χημειοθεραπεία που έχει σαν αποτέλεσμα και διάφορες άλλες παρενέργειες». Είπε, ότι οι νανοφορείς, εκτός της θεραπευτικής τους ιδιότητας, μπορούν να είναι και διαγωνιστικοί «δηλαδή να μεταφέρουν ένα διαγωνιστικό μέσο για να αυξήσουμε την ευαισθησία των ήδη υπαρχουσών απεικονιστικών τεχνικών, όπως της μαγνητικής τομογραφίας και των υπερήχων», είπε χαρακτηριστικά.
Οι τρεις πυλώνες της νανοϊατρικής και το επιγενετικό τεστ dna
Η νανοϊατρική έχει τρεις πυλώνες, την αναγεννητική ιατρική με τις βιοεκτυπώσεις, τους νανοφορείς δηλαδή τη δημιουργία των νανοσωματιδίων για στοχευόμενη μεταφορά φαρμάκων και τη βιοηλεκτρονική, δηλαδή τους βιοαισθητήρες.
Η αναγεννητική ιατρική, σύμφωνα με την κ. Καραγκιοζάκη, περιλαμβάνει την τελευταία εξέλιξη τις τρισδιάστατης εκτύπωσης που είναι η βιοεκτύπωση. «Μπορούμε να εκτυπώσουμε πεπτίδια και κύτταρα και να φτιάξουμε έναν ιστό και χόνδρο, μέχρι και ανθρώπινο αυτί», επισήμανε αι πρόσθεσε ότι «πρόσφατα εκτυπώσαμε ανθρώπινο δέρμα και το κάναμε αυτό γιατί μπορούμε να ελέγξουμε τους νανοφορείς που θα κατευθύνουμε σε αυτό και να μεταφέρουν αντιοξειδωτικούς παράγοντες για αντιγηραντικό αποτέλεσμα».
Βιοαισθητήρες υπάρχουν αυτοί που μπορούν να χρησιμοποιηθούν εκτός του ανθρώπινου οργανισμού και οι άλλοι εντός. Έτσι «αν είμαι διαβητική, αυτοί οι βιοαισθητήρες, μπορούν να μου ανιχνεύσουν τα επίπεδα ζαχάρου πριν πάθω υπογλυκαιμία και να πάρω έγκαιρα τη γλυκόζη για να αποφύγω το σοκ», διευκρίνισε.
Αναφερόμενη στην επιγενετική, λέγοντας ότι πρόκειται για το μέλλον της γενετικής, εξήγησε ότι είναι η επιστήμη που εξετάζει το πώς το περιβάλλον, οι περιβαλλοντικοί παράγοντες επιδρούν στο dna μας και αλλάζουν τη δράση των γονιδίων. Έτσι, ακόμη και αν κάποιος δεν έχει κληρονομικότητα ή γονιδιακή προδιάθεση για να εμφανίσει λόγου χάρη καρκίνο «οι εξωγενείς περιβαλλοντικοί παράγοντες, όπως κακή διατροφή και κάπνισμα, ρίχνουν το ανοσοποιητικό του και τον καθιστούν ευάλωτο σε διάφορες παθήσεις, όπως στον καρκίνο και στην covid-19».
Στην Ελλάδα υπάρχει διαθέσιμο επιγενετικό εξειδικευμένο τεστ dna, που ελέγχει 800 βιοδείκτες και διαγιγνώσκει τις ελλείψεις του ανθρώπινου οργανισμού και την προδιάθεση σε συγκεκριμένες νόσους.
Το επιστημονικό, ερευνητικό και επιχειρηματικό γεγονός «NANOTEXNOLOGY 2022», με έμφαση στον χώρο των τεχνολογιών αιχμής, της πράσινης ενέργειας, των εκτυπωμένων ηλεκτρονικών, της νανοϊατρικής και των προηγμένων υλικών, διεξάγεται αυτές τις μέρες στην Θεσσαλονίκη με την συμμετοχή 1000 συνέδρων από 65 χώρες.
Η νανοτεχνολογία, πέρα από τις επιστημονικές και τεχνολογικές ανακαλύψεις, δημιουργεί με τα προϊόντα και τις υπηρεσίες της μια τεράστια αγορά μεγέθους άνω των 6 τρισ. ευρώ για το 2021, η οποία εκτιμάται ότι θα υπερβεί φέτος τα 7,5 τρισ. ευρώ, όπως επίσης και περισσότερες από 1.500.000 νέες εταιρείες υψηλής τεχνολογίας και πολλές δεκάδες εκατομμύρια νέες θέσεις εργασίας σε όλους τους τομείς της παραγωγής, της οικονομίας και της κοινωνίας.
Κατά τις φετινές εργασίες που θα διαρκέσουν ώς τις 9 Ιουλίου, το 85% των συμμετεχόντων είναι παρόντες με φυσική παρουσία, ενώ οι συμμετοχές εταιρειών υψηλής τεχνολογίας από την Ελλάδα και το εξωτερικό στη NANOTEXNOLOGY EXPO, που διεξάγεται ζωντανά, ξεπέρασαν κάθε προσδοκία.